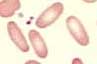

Definition:
Die Elliptozytose (oder Ovalozytose) ist eine heterogene Gruppe meist autosomal-dominant vererbter Störungen des Zytoskeletts, die durch vermehrtes Auftreten von Elliptozyten (mindestens 25%) charakterisiert sind. Die mit der Elliptozytose einhergehende Hämolyse ist meist mild, kann aber bei ungefähr 10% der Betroffenen zu einer symptomatischen Anämie führen.
Klinisches Bild:
Meist sind die Patienten asymptomatisch. Wie bei der Sphärozytose kann es zur Entwicklung von Gallensteinen kommen. Die Therapie der symptomatischen Form besteht in einer Splenektomie.
Hämatologie:
Der Anteil der Elliptozyten im Blut kann stark schwanken. Bei ausgeprägter Hämolyse findet man als Zeichen der vorzeitigen Ausschwemmung von Erythrozyten eine Polychromasie und basophil punktierte Erythrozyten.